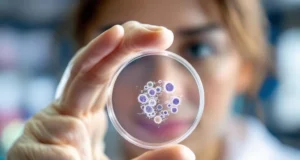
Lymphome : Le cancer du système immunitaire à ne pas négliger

DON'T MISS
« La plupart des gens s’éteignent à cette heure-là » : la révélation troublante...
Elle est surnommée "l'heure du lâcher-prise".
À domicile ou en établissements spécialisés, les soignants jouent un rôle clé auprès des personnes âgées et/ou malades, et...
Ces 5 symptômes précoces de la maladie d’Alzheimer qui doivent vous...
La maladie d’Alzheimer est une maladie mortelle du cerveau qui affecte la mémoire de la personne qui en souffre. Les symptômes de cette pathologie...
GADGET WORLD
Quels Aliments sont responsables du cancer du foie : découvrez la...
Une étude identifie les aliments très spécifiques comme principaux responsables des cancers du foie
Le foie, organe essentiel du métabolisme, possède une capacité d’adaptation face...
TRAVEL GUIDES
All
Covid : que sait-on des nouveaux vaccins bivalents ?
De nouveaux vaccins anti-Covid arrivent cette automne. Ce sont des vaccins bivalents, nouvelle génération. Que ...
Quelle est la difference entre un test pcr et antigenique?
Qui doit faire un test covid ? Le coronavirus est une maladie virale et infectieuse due au virus SARS-CoV-2. Cette ...
[td_block_social_counter facebook= »tagdiv » twitter= »tagdivofficial » youtube= »tagdiv » open_in_new_window= »y » border_top= »no_border_top »]
LATEST REVIEWS
Piratage de l’hôpital de Corbeille-Essonne : quel est le risque pour...
Les données des patients et du personnel de l’hôpital de Corbeille-Essonne ont été piratées. Quel est le ...
FASHION AND TRENDS
Boire de l’eau pour maigrir, ça marche vraiment ?
Il est courant d’entendre que boire de l’eau nous fait brûler des calories. Les études sont nombreuses ...
A quelle fréquence devez-vous laver votre pyjama ?
Pour les vêtements que nous portons près du corps, t-shirts, sous-vêtements ou chaussettes, nous ...